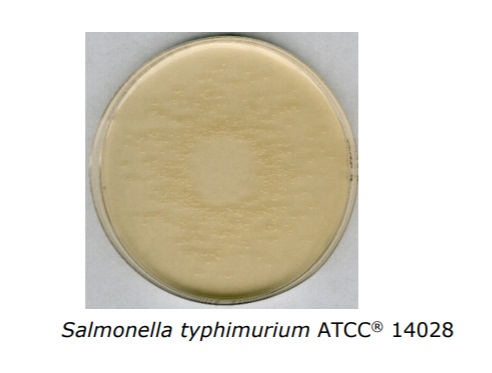
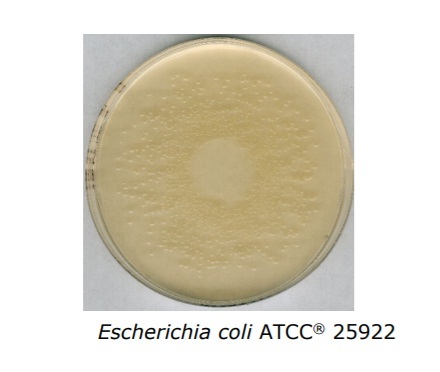

La gélose Nutritive est utilisée pour la culture de bactéries peu exigeantes.
Ce milieu de culture est conforme aux spécifications données par EN ISO 6579, EN ISO/FDIS
6579-1, EN ISO 6785 I IDF 93, EN ISO 10273, EN ISO 19250, EN ISO 21528 et APHA.
Géloses, Géloses Déshydratés (En poudre), Milieux de cultures
Gélose Nutritive 500 g Merck
17.017,00 د.ج
Selon ISO 6579, ISO 10273 and ISO 21528 GranuCult®
Marque: MERCK ![]()
Date de péremption: 04-2029
Rupture de stock
C'est intéressant, je partage:
| Poids | 0,5 kg |
|---|

Avis
Il n’y a pas encore d’avis.